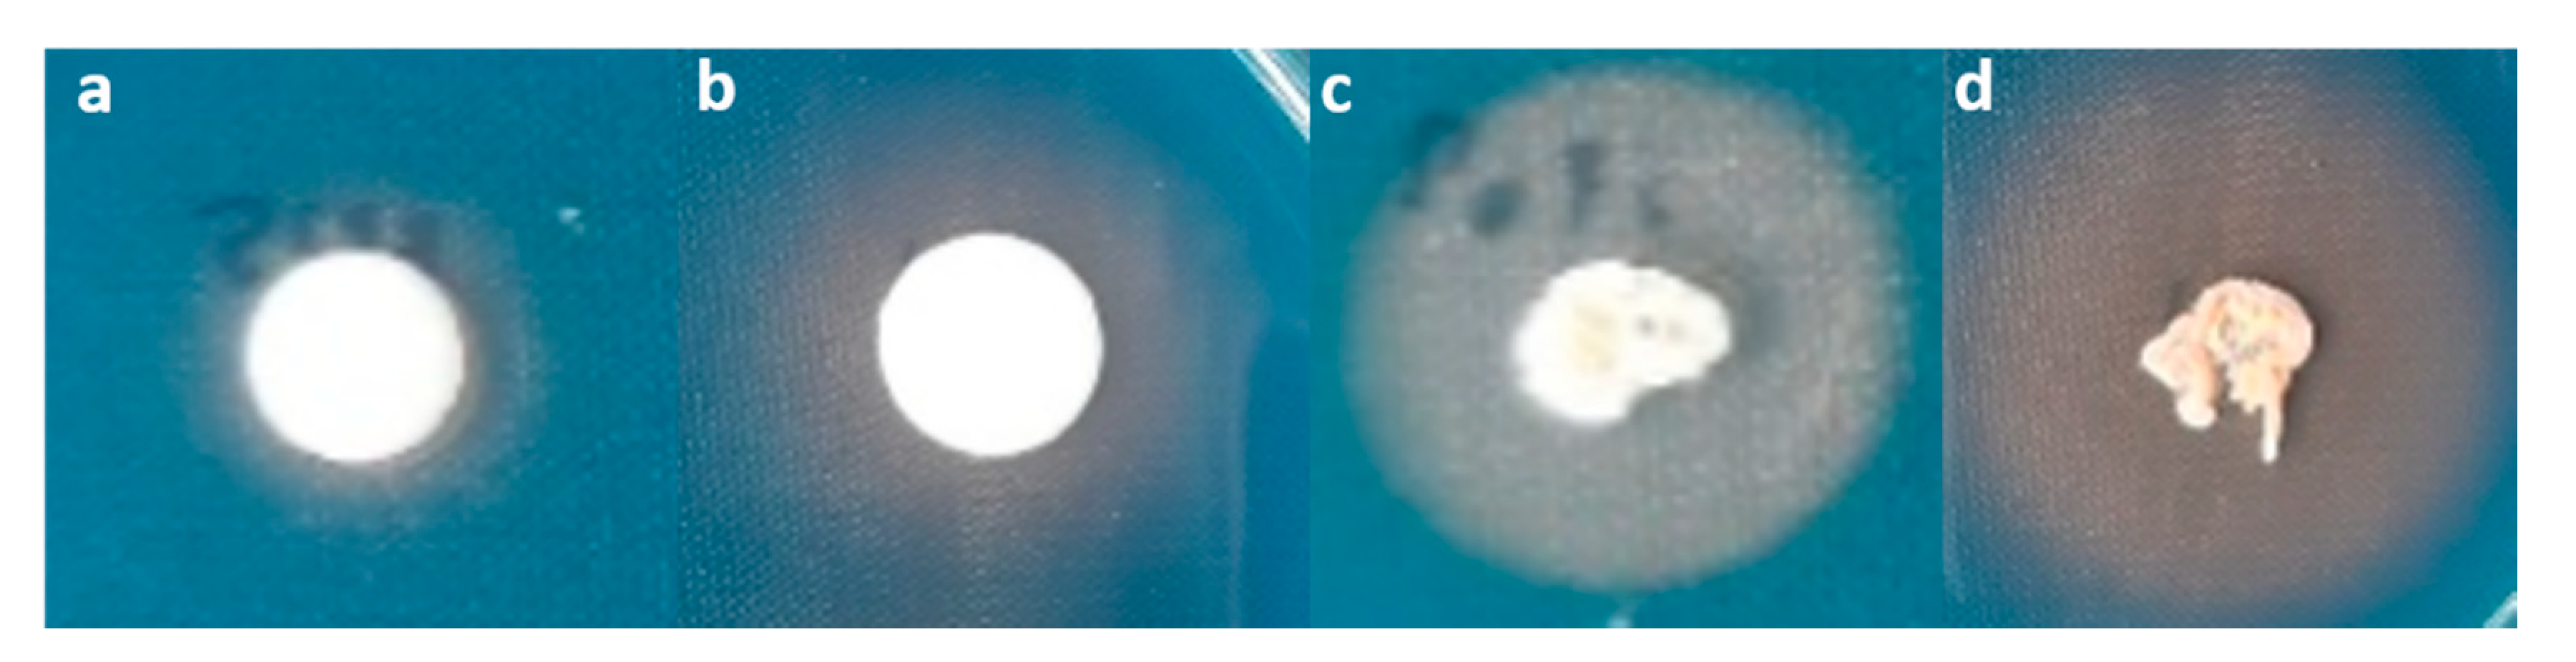

Biological Control of Fruit Rot and Anthracnose of Postharvest Mango by Antagonistic Yeasts from Economic Crops Leaves
Abstract
1. Introduction
2. Materials and Methods
2.1. Microorganisms and Cultivation
2.2. Selection of Antagonistic Yeasts Capable of Inhibiting Fungal Pathogens Causing Postharvest Mango Fruit Diseases
2.3. Determination of Antagonistic Mechanisms of Antagonistic Yeasts in Vitro
2.3.1. Production of Antifungal Volatile Organic Compounds
2.3.2. Competition for Nutrients
2.3.3. Siderophore Production
2.3.4. Biofilm Formation
2.4. Evaluation of the Efficacy of Antagonistic Yeasts in Controlling of Postharvest Diseases of Mango on Mango Fruit
2.5. Evaluation of the Efficacy of Antifungal Volatile Organic Compounds Produced by Antagonistic Yeasts in the Control of Postharvest Diseases of Mango on Mango Fruit
2.6. Statistical Analysis
3. Results
3.1. Selection of Antagonistic Yeasts Capable of Inhibiting Fungal Pathogens Causing Postharvest Mango Fruit Diseases
3.2. Determination of Antagonistic Mechanisms of Antagonistic Yeasts in Vitro
3.2.1. Production of Antifungal Volatile Organic Compounds
3.2.2. Competition for Nutrients
3.2.3. Siderophore Production
3.2.4. Biofilm Formation
3.3. Evaluation the Efficacy of Antagonistic Yeasts in Controlling of Postharvest Diseases of Mango on Mango Fruit
3.4. Evaluation the Efficacy of Antifungal Volatile Organic Compounds Produced by Antagonistic Yeasts in Controlling of Postharvest Diseases of Mango on Mango Fruit
4. Discussion
5. Conclusions
Supplementary Materials
Author Contributions
Funding
Conflicts of Interest
References
- Singh, Z.; Singh, S.P. Mango. In Crop PostHarvest: Science and Technology; Rees, D., Farrell, G., Orchard, J., Eds.; Wiley-Blackwell: Oxford, UK, 2012; Volume 3, pp. 108–142. [Google Scholar]
- Sivakumar, D.; Jiang, Y.; Yahia, E.M. Maintaining mango (Mangifera indica L.) fruit quality during the export chain. Food Res. Int. 2010, 44, 1254–1263. [Google Scholar] [CrossRef]
- Bally, I.S. Mangifera indica (mango). In Species Profiles for Pacific Island Agroforestry; Elevitch, C.R., Ed.; Permanent Agriculture Resources: Holualoa, HI, USA, 2006; pp. 1–25. [Google Scholar]
- De Souza-pollo, A.; De Goes, A. Mango Pathology and Diseases. In Handbook of Mango Fruit: Production, Postharvest Science, Processing Technology and Nutrition; Siddiq, M., Brecht, J.K., Sidhu, J.S., Eds.; Wiley-Blackwell: Oxford, UK, 2017; pp. 91–104. [Google Scholar]
- Zhang, J. Lasiodiplodia theobromae in Citrus Fruit (Diplodia Stem-End Rot). In Postharvest Decay: Control Strategies; Bautista-Banos, S., Ed.; Elsevier: London, UK, 2014; pp. 309–335. [Google Scholar]
- Siddiqui, Y.; Ali, A. Colletotrichum gloeosporioides (Anthracnose). In Postharvest Decay: Control Strategies; Bautista-Banos, S., Ed.; Elsevier: London, UK, 2014; pp. 337–371. [Google Scholar]
- Fu, W.; Tian, G.; Pei, Q.; Ge, X.; Tian, P. Evaluation of berberine as a natural compound to inhibit peach brown rot pathogen Monilinia fructicola. Crop Prot. 2017, 91, 20–26. [Google Scholar] [CrossRef]
- El Ghaouth, A.; Wilson, C.L.; Wisniewski, M. Control of postharvest decay of apple fruit with Candida saitoana and induction of defense responses. Phytopathology 2003, 93, 344–348. [Google Scholar] [CrossRef] [PubMed]
- Da Cunha, T.; Ferraz, L.P.; Wehr, P.P.; Kupper, K.C. Antifungal activity and action mechanisms of yeasts isolates from citrus against Penicillium italicum. Int. J. Food Microbiol. 2018, 276, 20–27. [Google Scholar] [CrossRef] [PubMed]
- Farbo, M.G.; Urgeghe, P.P.; Fiori, S.; Marcello, A.; Oggiano, S.; Balmas, V.; Hassan, Z.U.; Jaoua, S.; Migheli, Q. Effect of yeast volatile organic compounds on ochratoxin A-producing Aspergillus carbonarius and A. ochraceus. Int. J. Food Microbiol. 2018, 284, 1–10. [Google Scholar] [CrossRef]
- Spadaro, D.; Droby, S. Development of biocontrol products for postharvest diseases of fruit: The importance of elucidating the mechanisms of action of yeast antagonists. Trends Food Sci. Technol. 2016, 47, 39–49. [Google Scholar] [CrossRef]
- Zhou, Y.; Li, W.; Zeng, J.; Shao, Y. Mechanisms of action of the yeast Debaryomyces nepalensis for control of the pathogen Colletotrichum gloeosporioides in mango fruit. Biol. Control 2018, 123, 111–119. [Google Scholar] [CrossRef]
- Zhou, Y.; Li, S.; Zeng, K. Exogenous nitric oxide-induced postharvest disease resistance in citrus fruit to Colletotrichum gloeosporioides. J. Sci. Food Agr. 2016, 96, 505–512. [Google Scholar] [CrossRef]
- Bautista-Rosales, P.U.; Calderon-Santoyo, M.; Servín-Villegas, R.; Ochoa-Álvarez, N.A.; Ragazzo-Sánchez, J.A. Action mechanisms of the yeast Meyerozyma caribbica for the control of the phytopathogen Colletotrichum gloeosporioides in mangoes. Biol. Control 2013, 65, 293–301. [Google Scholar] [CrossRef]
- Bautista-Rosales, P.U.; Calderon-Santoyo, M.; Servín-Villegas, R.; Ochoa-Álvarez, N.A.; Vázquez-Juárez, R.; Ragazzo-Sánchez, J.A. Biocontrol action mechanisms of Cryptococcus laurentii on Colletotrichum gloeosporioides of mango. Crop Prot. 2014, 65, 194–201. [Google Scholar] [CrossRef]
- Gava, C.A.T.; De Castro, A.P.C.; Pereira, C.A.; Fernandes-Júnior, P.I. Isolation of fruit colonizer yeasts and screening against mango decay caused by multiple pathogens. Biol. Control 2018, 117, 137–146. [Google Scholar] [CrossRef]
- Mohamed, H.; Saad, A. The biocontrol of postharvest disease (Botryodiplodia theobromae) of guava (Psidium guajava L.) by the application of yeast strains. Postharvest Biol. Technol. 2009, 53, 123–130. [Google Scholar] [CrossRef]
- Khunnamwong, P.; Jindamorakot, S.; Limtong, S. Endophytic yeast diversity in leaf tissue of rice, corn and sugarcane cultivated in Thailand assessed by a culture-dependent approach. Fungal Biol. 2018, 122, 785–799. [Google Scholar] [CrossRef] [PubMed]
- Srisuk, N.; Nutaratat, P.; Surussawadee, J.; Limtong, S. Yeast communities in sugarcane phylloplane. Microbiology 2019, 88, 353–369. [Google Scholar] [CrossRef]
- Into, P.; Pontes, A.; Sampaio, J.P.; Limtong, S. Yeast diversity associated with the phylloplane of corn plants cultivated in Thailand. Microorganisms 2020, 8, 80. [Google Scholar] [CrossRef] [PubMed]
- Rosa, M.M.; Tauk-Tornisielo, S.M.; Rampazzo, P.E.; Ceccato-Antonini, S.R. Evaluation of the biological control by the yeast Torulaspora globosa against Colletotrichum sublineolum in sorghum. World J. Microbiol. Biotechnol. 2010, 26, 1491–1502. [Google Scholar] [CrossRef]
- Di Francesco, A.; Ugolini, L.; Lazzeri, L.; Mari, M. Production of volatile organic compounds by Aureobasidium pullulans as a potential mechanism of action against postharvest fruit pathogens. Biol. Control 2015, 81, 8–14. [Google Scholar] [CrossRef]
- Zhang, D.; Spadaro, D.; Garibaldi, A.; Gullino, M.L. Efficacy of the antagonist Aureobasidium pullulans PL5 against postharvest pathogens of peach, apple and plum and its modes of action. Biol. Control 2010, 54, 172–180. [Google Scholar] [CrossRef]
- Louden, B.C.; Haarmann, D.; Lynne, A.M. Use of blue agar CAS assay for siderophore detection. J. Microbiol. Biol. Educ. JMBE 2011, 12, 51. [Google Scholar] [CrossRef]
- Růžička, F.; Hola, V.; Votava, M.; Tejkalova, R. Importance of biofilm in Candida parapsilosis and evaluation of its susceptibility to antifungal agents by colorimetric method. Folia Microbiol. 2007, 52, 209. [Google Scholar] [CrossRef]
- Stepanović, S.; Vuković, D.; Hola, V.; Bonaventura, G.D.; Djukić, S.; Ćirković, I.; Ruzicka, F. Quantification of biofilm in microtiter plates: Overview of testing conditions and practical recommendations for assessment of biofilm production by staphylococci. Apmis 2007, 115, 891–899. [Google Scholar] [CrossRef]
- Nadai, C.; Junior, W.J.F.L.; Favaron, F.; Giacomini, A.; Corich, V. Biocontrol activity of Starmerella bacillaris yeast against blue mold disease on apple fruit and its effect on cider fermentation. PLoS ONE 2018, 13, e0204350. [Google Scholar] [CrossRef]
- Liu, J.; Sui, Y.; Wisniewski, M.; Droby, S.; Liu, Y. Utilization of antagonistic yeasts to manage postharvest fungal diseases of fruit. Int. J. Food Microbiol. 2013, 167, 153–160. [Google Scholar] [CrossRef]
- Hernández-Montiel, L.G.; Ochoa, J.L.; Troyo-Diéguez, E.; Larralde-Corona, C.P. Biocontrol of postharvest blue mold (Penicillium italicum Wehmer) on Mexican lime by marine and citrus Debaryomyces hansenii isolates. Postharvest Biol. Technol. 2010, 56, 181–187. [Google Scholar] [CrossRef]
- Zhang, D.; Spadaro, D.; Garibaldi, A.; Gullino, M.L. Potential biocontrol activity of a strain of Pichia guilliermondii against grey mold of apples and its possible modes of action. Biol. Control 2011, 57, 193–201. [Google Scholar] [CrossRef]
- Vero, S.; Garmendia, G.; González, M.B.; Bentancur, O.; Wisniewski, M. Evaluation of yeasts obtained from Antarctic soil samples as biocontrol agents for the management of postharvest diseases of apple (Malus× domestica). FEMS Yeast Res. 2013, 13, 189–199. [Google Scholar] [CrossRef]
- Habiba; Noreen, R.; Ali, S.A.; Hasan, K.A.; Sultana, V.; Ara, J.; Ehteshamul-Haque, S. Evaluation of biocontrol potential of epiphytic yeast against postharvest Penicillium digitatum rot of stored Kinnow fruit (Citrus reticulata) and their effect on its physiochemical properties. Postharvest Biol. Technol. 2019, 148, 38–48. [Google Scholar] [CrossRef]
- Kefialew, Y.; Ayalew, A. Postharvest biological control of anthracnose (Colletotrichum gloeosporioides) on mango (Mangifera indica). Postharvest Biol. Technol. 2008, 50, 8–11. [Google Scholar] [CrossRef]
- de Lima, J.R.; Gonçalves, L.R.B.; Brandão, L.R.; Rosa, C.A.; Viana, F.M.P. Isolation, identification, and activity in vitro of killer yeasts against Colletotrichum gloeosporioides isolated from tropical fruits. J. Basic Microbiol. 2013, 53, 590–599. [Google Scholar] [CrossRef]
- Campos-Martínez, A.; Velázquez-del Valle, M.G.; Flores-Moctezuma, H.E.; Suárez-Rodríguez, R.; Ramírez-Trujillo, J.A.; Hernández-Lauzardo, A.N. Antagonistic yeasts with potential to control Colletotrichum gloeosporioides (Penz.) Penz. & Sacc. and Colletotrichum acutatum JH Simmonds on avocado fruits. Crop Prot. 2016, 89, 101–104. [Google Scholar]
- Korpi, A.; Järnberg, J.; Pasanen, A.L. Microbial volatile organic compounds. Crit. Rev. Toxicol. 2009, 39, 139–193. [Google Scholar] [CrossRef] [PubMed]
- Parafati, L.; Vitale, A.; Restuccia, C.; Cirvilleri, G. Biocontrol ability and action mechanism of food-isolated yeast strains against Botrytis cinerea causing post-harvest bunch rot of table grape. Food Microbiol. 2015, 47, 85–92. [Google Scholar] [CrossRef] [PubMed]
- Huang, R.; Li, G.Q.; Zhang, J.; Yang, L.; Che, H.J.; Jiang, D.H.; Huang, H.C. Control of postharvest Botrytis fruit rot of strawberry by volatile organic compounds of Candida intermedia. Phytopathology 2011, 101, 859–869. [Google Scholar] [CrossRef]
- Huang, R.; Che, H.J.; Zhang, J.; Yang, L.; Jiang, D.H.; Li, G.Q. Evaluation of Sporidiobolus pararoseus strain YCXT3 as biocontrol agent of Botrytis cinerea on post-harvest strawberry fruits. Biol. Control 2012, 62, 53–63. [Google Scholar] [CrossRef]
- Janisiewicz, W.J.; Tworkoski, T.J.; Sharer, C. Characterizing the mechanism of biological control of postharvest diseases on fruits with a simple method to study competition for nutrients. Phytopathology 2000, 90, 1196–1200. [Google Scholar] [CrossRef]
- Freimoser, F.M.; Rueda-Mejia, M.P.; Tilocca, B.; Migheli, Q. Biocontrol yeasts: Mechanisms and applications. World J. Microbiol. Biotechnol. 2019, 35, 154. [Google Scholar] [CrossRef]
- Saravanakumar, D.; Ciavorella, A.; Spadaro, D.; Garibaldi, A.; Gullino, M.L. Metschnikowia pulcherrima strain MACH1 outcompetes Botrytis cinerea, Alternaria alternata and Penicillium expansum in apples through iron depletion. Postharvest Biol. Technol. 2008, 49, 121–128. [Google Scholar] [CrossRef]
- Calvente, V.; Benuzzi, D.; Tosetti, M.I.S. Antagonistic action of siderophores from Rhodotorul aglutinis upon the postharvest pathogen Penicillium expansum. Int. Biodeter. Biodegr. 1999, 43, 167–172. [Google Scholar] [CrossRef]
- Khunnamwong, P.; Lertwattanasakul, N.; Jindamorakot, S.; Suwannarach, N.; Matsui, K.; Limtong, S. Evaluation of antagonistic activity and mechanisms of endophytic yeasts against pathogenic fungi causing economic crop diseases. Folia Microbiol. 2019, 64, 1–18. [Google Scholar] [CrossRef]
- Annous, B.A.; Fratamico, P.M.; Smith, J.L. Scientific status summary: Quorum sensing in biofilms: Why bacteria behave the way they do. J. Food Sci. 2009, 74, R24–R37. [Google Scholar] [CrossRef]
- Fiori, S.; Fadda, A.; Giobbe, S.; Berardi, E.; Migheli, Q. Pichia angusta is an effective biocontrol yeast against postharvest decay of apple fruit caused by Botrytis cinerea and Monilia fructicola. FEMS Yeast Res. 2008, 8, 961–963. [Google Scholar] [CrossRef] [PubMed]
- Ianiri, G.; Idnurm, A.; Wright, S.A.; Durán-Patrón, R.; Mannina, L.; Ferracane, R.; Ritieni, A.; Castoria, R. Searching for genes responsible for patulin degradation in a biocontrol yeast provides insight into the basis for resistance to this mycotoxin. Appl. Environ. Microbiol. 2013, 79, 3101–3115. [Google Scholar] [CrossRef] [PubMed]
- Giobbe, S.; Marceddu, S.; Scherm, B.; Zara, G.; Mazzarello, V.L.; Budroni, M.; Migheli, Q. The strange case of a biofilm-forming strain of Pichia fermentans, which controls Monilinia brown rot on apple but is pathogenic on peach fruit. FEMS Yeast Res. 2007, 7, 1389–1398. [Google Scholar] [CrossRef]
- Aubert, C.; Bony, P.; Chalot, G.; Hero, V. Changes in physicochemical characteristics and volatile compounds of apricot (Prunus armeniaca L. cv. Bergeron) during storage and post-harvest maturation. Food Chem. 2010, 119, 1386–1398. [Google Scholar] [CrossRef]
- Wei, Y.Y.; Mao, S.B.; Tu, K. Effect of preharvest spraying Cryptococcus laurentii on postharvest decay and quality of strawberry. Biol. Control 2014, 73, 68–74. [Google Scholar] [CrossRef]
- Luo, S.; Wan, B.; Feng, S.; Shao, Y. Biocontrol of postharvest anthracnose of mango fruit with Debaryomyces nepalensis and effects on storage quality and postharvest physiology. J. Food Sci. 2015, 80, M2555–M2563. [Google Scholar] [CrossRef]
- Tian, Y.Q.; Li, W.; Jiang, Z.T.; Jing, M.M.; Shao, Y.Z. The preservation effect of Metschnikowia pulcherrima yeast on anthracnose of postharvest mango fruits and the possible mechanism. Food Sci. Biotechnol. 2018, 27, 95–105. [Google Scholar] [CrossRef]
- Sharma, R.R.; Singh, D.; Singh, R. Biological control of postharvest diseases of fruits and vegetables by microbial antagonists: A review. Biol. Control 2009, 50, 205–221. [Google Scholar] [CrossRef]
- Reyes, M.E.Q.; Rohrbach, K.G.; Paull, R.E. Microbial antagonists control postharvest black rot of pineapple fruit. Postharvest Biol. Technol. 2004, 33, 193–203. [Google Scholar] [CrossRef]
- Liu, J.; Wisniewski, M.; Droby, S.; Tian, S.; Hershkovitz, V.; Tworkoski, T. Effect of heat shock treatment on stress tolerance and biocontrol efficacy of Metschnikowia fructicola. FEMS Microbiol. Ecol. 2011, 76, 145–155. [Google Scholar] [CrossRef]
- Liu, F.; Tu, K.; Shao, X.; Zhao, Y.; Tu, S.; Su, J.; Hou, Y.; Zou, X. Effect of hot air treatment in combination with Pichia guilliermondii on postharvest anthracnose rot of loquat fruit. Postharvest Biol. Technol. 2010, 58, 65–71. [Google Scholar] [CrossRef]
- Zhang, C.; Chen, K.; Wang, G. Combination of the biocontrol yeast Cryptococcus laurentii with UV-C treatment for control of postharvest diseases of tomato fruit. Biocontrol 2013, 58, 269–281. [Google Scholar] [CrossRef]
- Yu, T.; Chen, J.; Lu, H.; Zheng, X. Indole-3-acetic acid improves postharvest biological control of blue mold rot of apple by Cryptococcus laurentii. Phytopathology 2009, 99, 258–264. [Google Scholar] [CrossRef]
- Zhang, H.; Ma, L.; Wang, L.; Jiang, S.; Dong, Y.; Zheng, X. Biocontrol of gray mold decay in peach fruit by integration of antagonistic yeast with salicylic acid and their effects on postharvest quality parameters. Biol. Control 2008, 47, 60–65. [Google Scholar] [CrossRef]
- Melin, P.; Schnürer, J.; Håkansson, S. Formulation and stabilisation of the biocontrol yeast Pichia anomala. Antonie Leeuwenhoek 2011, 99, 107–112. [Google Scholar] [CrossRef]

| Treatment | Fungal Pathogens Growth Inhibition (%) a | |||
|---|---|---|---|---|
| 39.0 g/L PDA Powder | 19.5 g/L PDA Powder | 9.7 g/L PDA Powder | 3.9 g/L PDA Powder | |
| T. indica DMKU-RP31 + L. theobromae | 65.6 ± 1.87bc | 67.3 ± 0.99b | 70.8 ± 1.69ab | 75.6 ± 3.24a |
| T. indica DMKU-RP35 + L. theobromae | 67.7 ± 0.90b | 68.6 ± 0.57b | 70.8 ± 3.56ab | 76.0 ± 4.68a |
| Ps. hubeiensis YE-21 + L. theobromae | 58.4 ± 1.87d | 61.7 ± 1.14cd | 62.0 ± 3.56cd | 69.7 ± 5.15b |
| P. aspenensis DMKU-SP67 + C. gloeosporiodes | 64.6 ± 3.72c | 68.1 ± 0.57bc | 71.3 ± 1.71b | 75.7 ± 1.36a |
| Treatment | Siderophore (Yellow Zone Diameter, mm) a | Biofilm Formation | ||
|---|---|---|---|---|
| OD600 (Average ± SD) | OD Value b | Level c | ||
| Control c | nd | 0.079 ± 0.00 | - | - |
| T. indica DMKU-RP31 | 7.83 ± 0.76 | 0.192 ± 0.05 | 2.4303 | Moderate |
| T. indica DMKU-RP35 | 6.33 ± 0.58 | 0.552 ± 0.03 | 6.9873 | Strong |
| Ps. hubeiensis YE-21 | 12.67 ± 1.15 | 0.092 ± 0.01 | 1.1645 | Weak |
| P. aspenensis DMKU-SP67 | 9.67 ± 0.58 | 0.103 ± 0.01 | 1.3037 | Weak |
| Treatments | Yeast Cells | VOCs | ||
|---|---|---|---|---|
| Wound Diameter (mm) a | Disease Severity Reduction (%) b | Wound Diameter (mm) a | Disease Severity Reduction (%) b | |
| Fruit Rot | ||||
| L. theobromae (positive control) | 50.7 ± 1.37 | 0 | 57.2 ± 5.30 | 0 |
| L. theobromae + T. indica DMKU-RP31 | 24.2 ± 1.74 | 52.7 ± 2.66b | 39.2 ± 5.56 | 31.5 ± 0.97b |
| L. theobromae + T. indica DMKU-RP35 | 8.5 ± 0.16 | 82.4 ± 5.64a | 26.8 ± 2.08 | 53.1 ± 1.36a |
| L. theobromae + Ps. hubeiensis YE-21 | 20.2 ± 1.09 | 49.5 ± 3.89b | 46.2 ± 2.97 | 19.2 ± 1.52c |
| L. theobromae + Benomyl | 8.3 ± 0.55 | 87.5 ± 4.32a | nd | nd |
| Anthracnose | ||||
| C. gloeosporiodes (positive control) | 29.6 ± 0.68 | 0 | 57.0 ± 4.73 | 0 |
| C. gloeosporiodes + P. aspenensis DMKU-SP67 | 1.7 ± 0.53 | 94.1 ± 0.18a | 29.3 ± 0.88 | 48.5 ± 0.15 |
| C. gloeosporiodes + Benomyl | 1.7 ± 0.42 | 93.9 ± 3.32a | nd | nd |
© 2020 by the authors. Licensee MDPI, Basel, Switzerland. This article is an open access article distributed under the terms and conditions of the Creative Commons Attribution (CC BY) license (http://creativecommons.org/licenses/by/4.0/).
Share and Cite
Konsue, W.; Dethoup, T.; Limtong, S. Biological Control of Fruit Rot and Anthracnose of Postharvest Mango by Antagonistic Yeasts from Economic Crops Leaves. Microorganisms 2020, 8, 317. https://doi.org/10.3390/microorganisms8030317
Konsue W, Dethoup T, Limtong S. Biological Control of Fruit Rot and Anthracnose of Postharvest Mango by Antagonistic Yeasts from Economic Crops Leaves. Microorganisms. 2020; 8(3):317. https://doi.org/10.3390/microorganisms8030317
Chicago/Turabian StyleKonsue, Wilasinee, Tida Dethoup, and Savitree Limtong. 2020. "Biological Control of Fruit Rot and Anthracnose of Postharvest Mango by Antagonistic Yeasts from Economic Crops Leaves" Microorganisms 8, no. 3: 317. https://doi.org/10.3390/microorganisms8030317
APA StyleKonsue, W., Dethoup, T., & Limtong, S. (2020). Biological Control of Fruit Rot and Anthracnose of Postharvest Mango by Antagonistic Yeasts from Economic Crops Leaves. Microorganisms, 8(3), 317. https://doi.org/10.3390/microorganisms8030317

